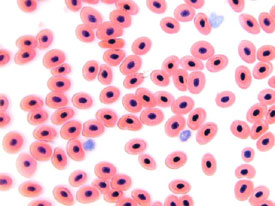
Microscope frog's blood 400x

| These images were all captured with a digital student microscope. This microscope is a great introductory microscope for elementary students. The microscope includes software and plugs directly into the USB port on the computer. You can view a live image on the computer and capture and save images. |
Both of these images of frog's blood were captured with a digital student microscope. The image at left was captured at 100x magnification. The image on the right was captured with 400x magnification.
Spider image under the microscope, captured at 40x magnification.

|